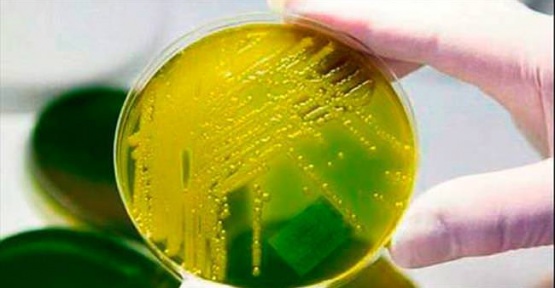

ABD, de yapılan araştırmalar ışığında bakterilerin artık ilaçlardan etkilenmediği ve antibiyotiğe karşı daha da dirençli oldukları ortaya çıktı. Özellikle kadınlarda bu bakteri tesbit edilirken, tedavisinin olmamasıda ayrı bir korkuya yol açtı. Sonuç olarak bu vakalarda dirençli bakteriler yüzünden can kayıpları meydana gelme riski artacak ve bilim adamları süper dirençli bakteriler için “nasıl antibiyotiğe duyarlı hale gelebilir” sorusuna yönelik çalışmalara başladılar.

Çinli Bilim Adamları Derdimize Çare Oldu İnsanlarda, domuzda ve yeni tür olan antibiyotiğe dayanıklı süper dirençli bakteriler üzerine yaptıkları çalışmalar meyvelerini verdi. Bilim adamlarına göre, salgın hastalıklı popilasyonda bazı bakterilerin (özellikle, Klebsiella pneumoniae ve Escherichia coli bakterileri) genlerinde meydana gelen değişim sonucu ”MCR-1” adı verilen gen; kendi kendine çoğalabilien, kromozomlardan ayrı kendine has DNA dizilimi olan bir tür plazmidler olduğunu belirledi. Bu plazmidlerin tehlikeli olduklarını; idrar yolu hastalıkları olan E-coli hastalığından zatürreye kadar ağır hastalıklara neden olan süper dirençli bakteriler olduğunun tesbitine varmışlardır.
Bu Bakterilerden Nasıl Korunacağız? Bilim adamlarının belirttiği ölçüde bu bakteriler için antibiyotiklere güç verecek ve yardımcı olacak ilaçlar üretimi yapılacaktır. Prof. Luca Guardabassi, “Artık süper dirençli bakteriler nasıl yeneceğimi bulduk. Artık onları daha iyi tanıyor ve nasıl alt edeceğimizi biliyoruz” şeklinde açıklaması ile endişelere son verdi. Araştırmalar ve demeçler lancet dergisinde yayınlanmış ve Birmingham Üniversitesi Mikrobiyoloji dali Profösörü Laura Piddock tarafından, “çiftlik hayvanlarında çok kullanılan antibiyotikler, bu tür bakterilerin mutasyonuna yol açacağını ve bir an önce önlem alınması gerektiriği ve gereksiz antibiyotik kullanımı durdurulmalı” şeklinde konuyla ilgili açıklaması yayınlandı. Ayrıca araştırma ve konu ile ilgili sonuçlar, Nature Dergisi`nde “Scientific Reports” olarak yayınlanmıştır.

Çinli Bilim Adamları Derdimize Çare Oldu İnsanlarda, domuzda ve yeni tür olan antibiyotiğe dayanıklı süper dirençli bakteriler üzerine yaptıkları çalışmalar meyvelerini verdi. Bilim adamlarına göre, salgın hastalıklı popilasyonda bazı bakterilerin (özellikle, Klebsiella pneumoniae ve Escherichia coli bakterileri) genlerinde meydana gelen değişim sonucu ”MCR-1” adı verilen gen; kendi kendine çoğalabilien, kromozomlardan ayrı kendine has DNA dizilimi olan bir tür plazmidler olduğunu belirledi. Bu plazmidlerin tehlikeli olduklarını; idrar yolu hastalıkları olan E-coli hastalığından zatürreye kadar ağır hastalıklara neden olan süper dirençli bakteriler olduğunun tesbitine varmışlardır.
Bu Bakterilerden Nasıl Korunacağız? Bilim adamlarının belirttiği ölçüde bu bakteriler için antibiyotiklere güç verecek ve yardımcı olacak ilaçlar üretimi yapılacaktır. Prof. Luca Guardabassi, “Artık süper dirençli bakteriler nasıl yeneceğimi bulduk. Artık onları daha iyi tanıyor ve nasıl alt edeceğimizi biliyoruz” şeklinde açıklaması ile endişelere son verdi. Araştırmalar ve demeçler lancet dergisinde yayınlanmış ve Birmingham Üniversitesi Mikrobiyoloji dali Profösörü Laura Piddock tarafından, “çiftlik hayvanlarında çok kullanılan antibiyotikler, bu tür bakterilerin mutasyonuna yol açacağını ve bir an önce önlem alınması gerektiriği ve gereksiz antibiyotik kullanımı durdurulmalı” şeklinde konuyla ilgili açıklaması yayınlandı. Ayrıca araştırma ve konu ile ilgili sonuçlar, Nature Dergisi`nde “Scientific Reports” olarak yayınlanmıştır.